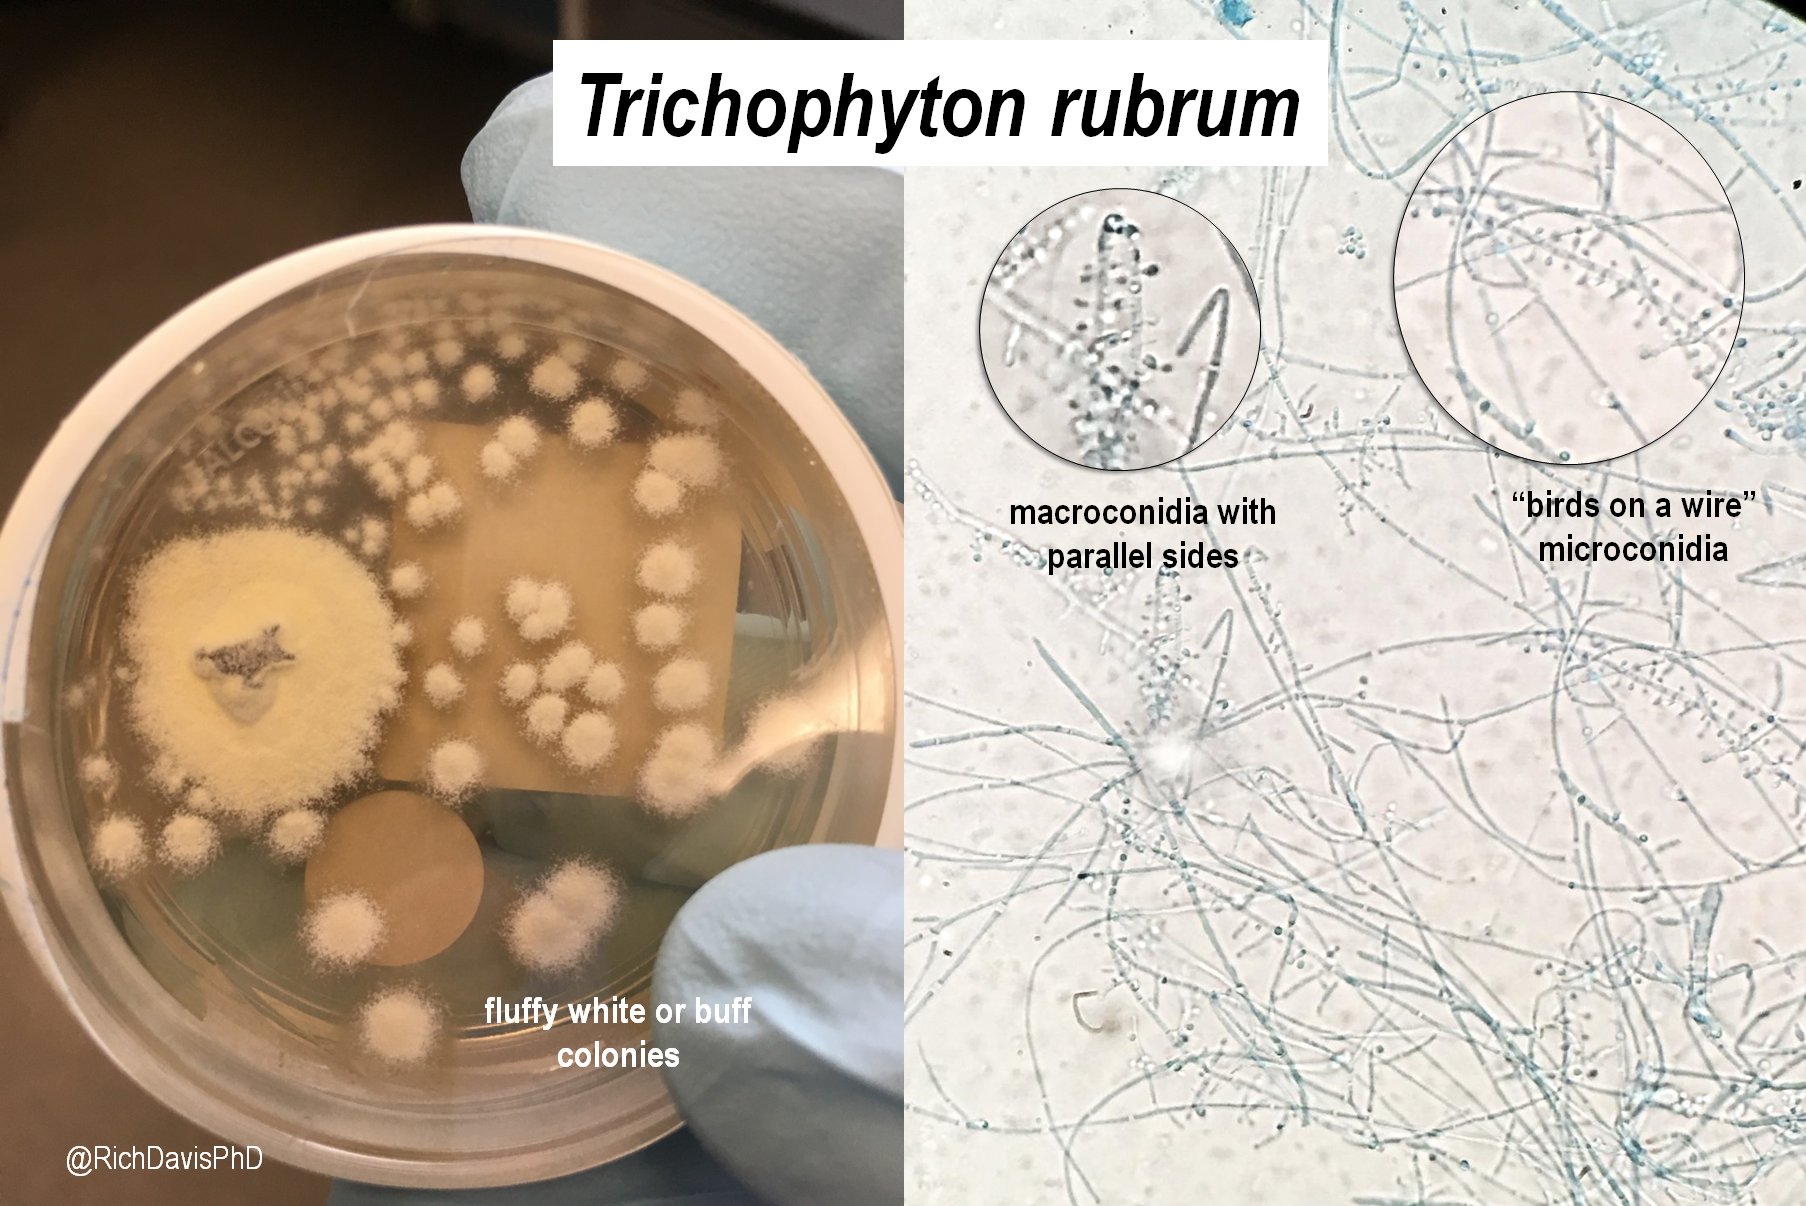

مرحبا بكَ زائرنا العزيز
يتيح للدرون تحقيق الاتزان الديناميكي في الهواء. عبر فرق السرعات بين المراوح…
مؤكدًا أن الاحترام للحياة والضمير العلمي أهم من المكاسب التجارية.
هذه الحادثة تم نسيانها إلى حد كبير في ذلك الوقت لأن الإعلام والاهتمام العام…
المجال مغناطيسي القوي في الرنين المغناطيسي ، يعطي صورًا دقيقة للأوتار والعضلات…
وقدرت المنظمة التكلفة السنوية اللازمة للقضاء على الفقر بالنسبة لـ 3.8 مليار شخص…
صفحة الكاتب الشخصية
منذ 5 دقائق نشر في ٢٠٢٥/١٢/١٣ م

منذ 10 دقائق نشر في ٢٠٢٥/١٢/١٣ م

منذ 2 أيام نشر في ٢٠٢٥/١٢/١١ م

منذ 2 أيام نشر في ٢٠٢٥/١٢/١١ م

منذ 3 أيام نشر في ٢٠٢٥/١٢/١٠ م

منذ 3 أيام نشر في ٢٠٢٥/١٢/١٠ م

منذ 4 أيام نشر في ٢٠٢٥/١٢/٠٩ م

منذ 4 أيام نشر في ٢٠٢٥/١٢/٠٩ م

منذ 5 أيام نشر في ٢٠٢٥/١٢/٠٨ م

منذ 5 أيام نشر في ٢٠٢٥/١٢/٠٨ م

منذ 6 أيام نشر في ٢٠٢٥/١٢/٠٧ م

منذ 6 أيام نشر في ٢٠٢٥/١٢/٠٧ م

منذ 7 أيام نشر في ٢٠٢٥/١٢/٠٦ م

منذ 1 أسابيع نشر في ٢٠٢٥/١٢/٠٦ م

منذ 1 أسابيع نشر في ٢٠٢٥/١٢/٠٤ م

منذ 1 أسابيع نشر في ٢٠٢٥/١٢/٠٤ م
منذ 1 أسابيع نشر في ٢٠٢٥/١٢/٠٣ م

منذ 1 أسابيع نشر في ٢٠٢٥/١٢/٠٣ م

منذ 2 أسابيع نشر في ٢٠٢٥/١٢/٠٢ م

منذ 2 أسابيع نشر في ٢٠٢٥/١٢/٠٢ م

منذ 2 أسابيع نشر في ٢٠٢٥/١٢/٠١ م

منذ 2 أسابيع نشر في ٢٠٢٥/١٢/٠١ م

منذ 2 أسابيع نشر في ٢٠٢٥/١١/٣٠ م

منذ 2 أسابيع نشر في ٢٠٢٥/١١/٣٠ م
